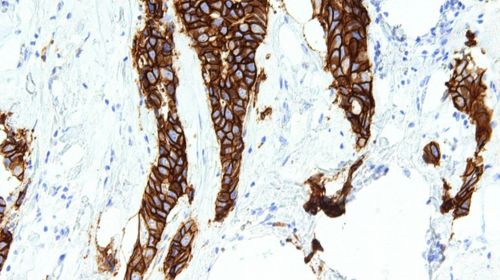

Abrir en el navegador
Abrir en el navegador
|

|

|
AseBio Te cuenta
|

|
La Fundación Parque Científico de Madrid otorga los II premios Health to Market de innovación en salud
La Fundación Parque Científico de Madrid (FPCM), junto con EIT Health Spain, ha anunciado hoy los ganadores de los II premios...
Continuar leyendo
|
|

|

|
Barcelona se consolida como sede de BIOSPAIN para las ediciones de 2025 y 2027
La Asociación Española de Bioempresas (AseBio) anuncia la celebración de BIOSPAIN en Barcelona para las ediciones de...
Continuar leyendo
|
|

|
Bioga Comunica
|

|
Agomab anuncia una ronda series D de $90M para apoyar a una amplia cartera de productos centrada en la fibrosis
Agomab Therapeutics NV ha anunciado hoy el cierre de una ronda de financiación Serie D de 90 millones de dólares (82,1 millones...
Continuar leyendo
|
|

|
TERAV, innovación española en Terapias Avanzadas
|

|
Avances en inmunoterapia y terapia génica: Reunión Anual TERAV 2024 se celebra en Alicante
Los próximos 21 y 22 de noviembre, Alicante será la sede de la Reunión Anual TERAV 2024, un evento que reunirá...
Continuar leyendo
|
|

|

|
Actualidad de Farmabiotec
|

|
España no avanza en la financiación de terapias oncológicas recomendadas por la ESMO
España sigue sin progresar en la financiación pública de terapias oncológicas recomendadas por la Sociedad Europea...
Continuar leyendo
|
|

|

|
El XVIII Congreso LABCLIN 2024 aborda el papel de la Medicina de Laboratorio en el diagnóstico y tratamiento del cáncer de pulmón
El cáncer de pulmón es responsable de 1,8 millones de muertes anuales a nivel mundial y representa el 17,8% de los fallecimientos...
Continuar leyendo
|
|

|
Investigadores del IBV-CSIC identifican el impacto del gen Tet3 en enfermedades metabólicas
Un grupo de investigación internacional, liderado por el Instituto de Biomedicina de Valencia (IBV-CSIC), ha demostrado que la ausencia...
Continuar leyendo
|
|

|

|
Jornada anual del PRAN: reducción del uso de antibióticos y cooperación internacional en el Día Europeo para el Uso Prudente de los Antibióticos
El Plan Nacional frente a la Resistencia a los Antibióticos (PRAN), coordinado por la AEMPS, ha conmemorado una década...
Continuar leyendo
|
|

|
Terapia celular en Parkinson: estudio revela avances en neuroprotección y neurogénesis
La enfermedad de Parkinson, la segunda enfermedad neurodegenerativa más común del mundo, carece actualmente de cura, y los...
Continuar leyendo
|
|

|

|
Adamed SmartUP Academy celebra su tercera edición en España durante la Semana de la Ciencia 2024
Adamed Laboratorios, en colaboración con la Universidad de Alcalá (UAH), ha llevado a cabo con éxito la tercera edición...
Continuar leyendo
|
|

|
Theriva Biologics completa inscripción en su ensayo Fase 2b para cáncer de páncreas y evalúa expansión a Fase 3
Theriva Biologics, compañía en fase clínica enfocada en terapias innovadoras para tratar el cáncer y enfermedades...
Continuar leyendo
|
|

|

|
La investigación del IBV-CSIC abre nuevas vías para desarrollar antidepresivos más efectivos y tratamientos contra el cáncer
Un equipo internacional de investigación, liderado por el Instituto de Biomedicina de Valencia (IBV-CSIC) del Consejo Superior de...
Continuar leyendo
|
|

|
IQS debate sobre el futuro de las start-ups frente a las grandes corporaciones de Ciencias de la Vida
El pasado 6 de noviembre, IQS acogió la mesa redonda “David contra Goliat: Creación y posibilidades de éxito...
Continuar leyendo
|
|

|

|
Identifican genes que ayudarían a predecir el pronóstico del cáncer de mama
Un equipo internacional de investigación, que incluye a científicos del Centro de Investigación del Cáncer,...
Continuar leyendo
|
|

|
Merck celebra 100 años en España y 35 de innovación biotecnológica en Tres Cantos
Con motivo de su 100º aniversario en España y el 35º aniversario de su planta biotecnológica en Madrid, la compañía...
Continuar leyendo
|
|

|

|
Descubren receptor clave en la enfermedad de Niemann-Pick tipo C, abriendo nuevas perspectivas terapéuticas
Un equipo liderado por el Centro de Biología Molecular Severo Ochoa (CBM-CSIC-UAM), en colaboración con el Consejo Superior...
Continuar leyendo
|
|

|
El Grupo Zendal entrega sus premios de salud humana y animal en una gala que llega a su V edición
La sede de AFundación en Vigo fue el escenario de la V edición de los Zendal International Awards, que celebró la entrega...
Continuar leyendo
|
|

|

|
SYNLAB lanza PGx TotalDx FullTech: un avance en la farmacogenética para tratamientos personalizados
SYNLAB ha lanzado PGx TotalDx FullTech, un innovador servicio de análisis farmacogenéticos diseñado para personalizar...
Continuar leyendo
|
|

|
#GlobalBiosimilarsWeek 2024: BioSim promueve el acceso a los biosimilares en su 5ª edición
La Asociación Internacional de Genéricos y Biosimilares (IGBA) ha lanzado la 5ª edición de #GlobalBiosimilarsWeek,...
Continuar leyendo
|
|

|

|

|
Artículos
|

|
Agitadores y equipos de limpieza de tanques que aportan grandes ahorros en el procesamiento biofarmacéutico
Uno de los mayores productores de insulina del mundo ha instalado alrededor de 250 agitadores Alfa Laval en casi todos sus tanques de mezcla. Esta configuración...
Artículo completo
|
|

|

|
Desarrollo de terapias CAR-T no virales: Por qué es fundamental un análisis eficaz del ecosistema de propiedad intelectual
La investigación, producción y comercialización de nuevas terapias suele estar vinculada a aplicaciones en enfermedades que, o bien aún...
Artículo completo
|
|

|
La biotecnología ocupa un papel destacado en las orientaciones políticas para la próxima Comisión Europea 2024-2029
El pasado 18 de julio de 2024, la presidenta de la Comisión Europea, Ursula von der Leyen, elegida para un segundo mandato en las elecciones celebradas...
Artículo completo
|
|

|
Eventos recomendados
|

|
Medicalforum
20/05/2025
Tlf. +34 91 630 85 91 / +34 672 050 625 - Mail comercial@medicalforum.es, Barcelona (España)
Más información
|
|

|
Farmaforum 2025
17/09/2025
IFEMA, Pabellón 9, Madrid (España)
Más información
|
|
Empresas premium
|

|
|
Este mensaje y sus adjuntos contienen información confidencial y reservada dirigida exclusivamente a su destinatario. Si ha recibido este mensaje por error, se ruega lo notifique inmediatamente por esta misma vía y borre el mensaje de su sistema. Nótese que el correo electrónico vía Internet no permite asegurar ni la confidencialidad de los mensajes que se transmiten ni la correcta recepción de los mismos. Los datos derivados de su correspondencia se incluyen en un fichero de titularidad de OMNIMEDIA, S.L. cuya finalidad exclusiva es gestionar las comunicaciones de la empresa entendiéndose que usted consiente el tratamiento de los mismos con dicha finalidad al mantener tal correspondencia. El ejercicio de sus derechos de acceso, rectificación, cancelación u oposición puede realizarlo dirigiéndose por escrito a la dirección C/ Pollensa, 2, Edif. Artemisa of. 12 de LA ROZAS (28290 - MADRID) adjuntando una fotocopia de su NIF o documento identificativo.
Este mensaje se ha enviado a {{ campaign.sender.email }} que está registrado dentro del listado de suscriptores de nuestra revista. Si no desea recibir más información y darse de baja de nuestros boletines click aquí
|